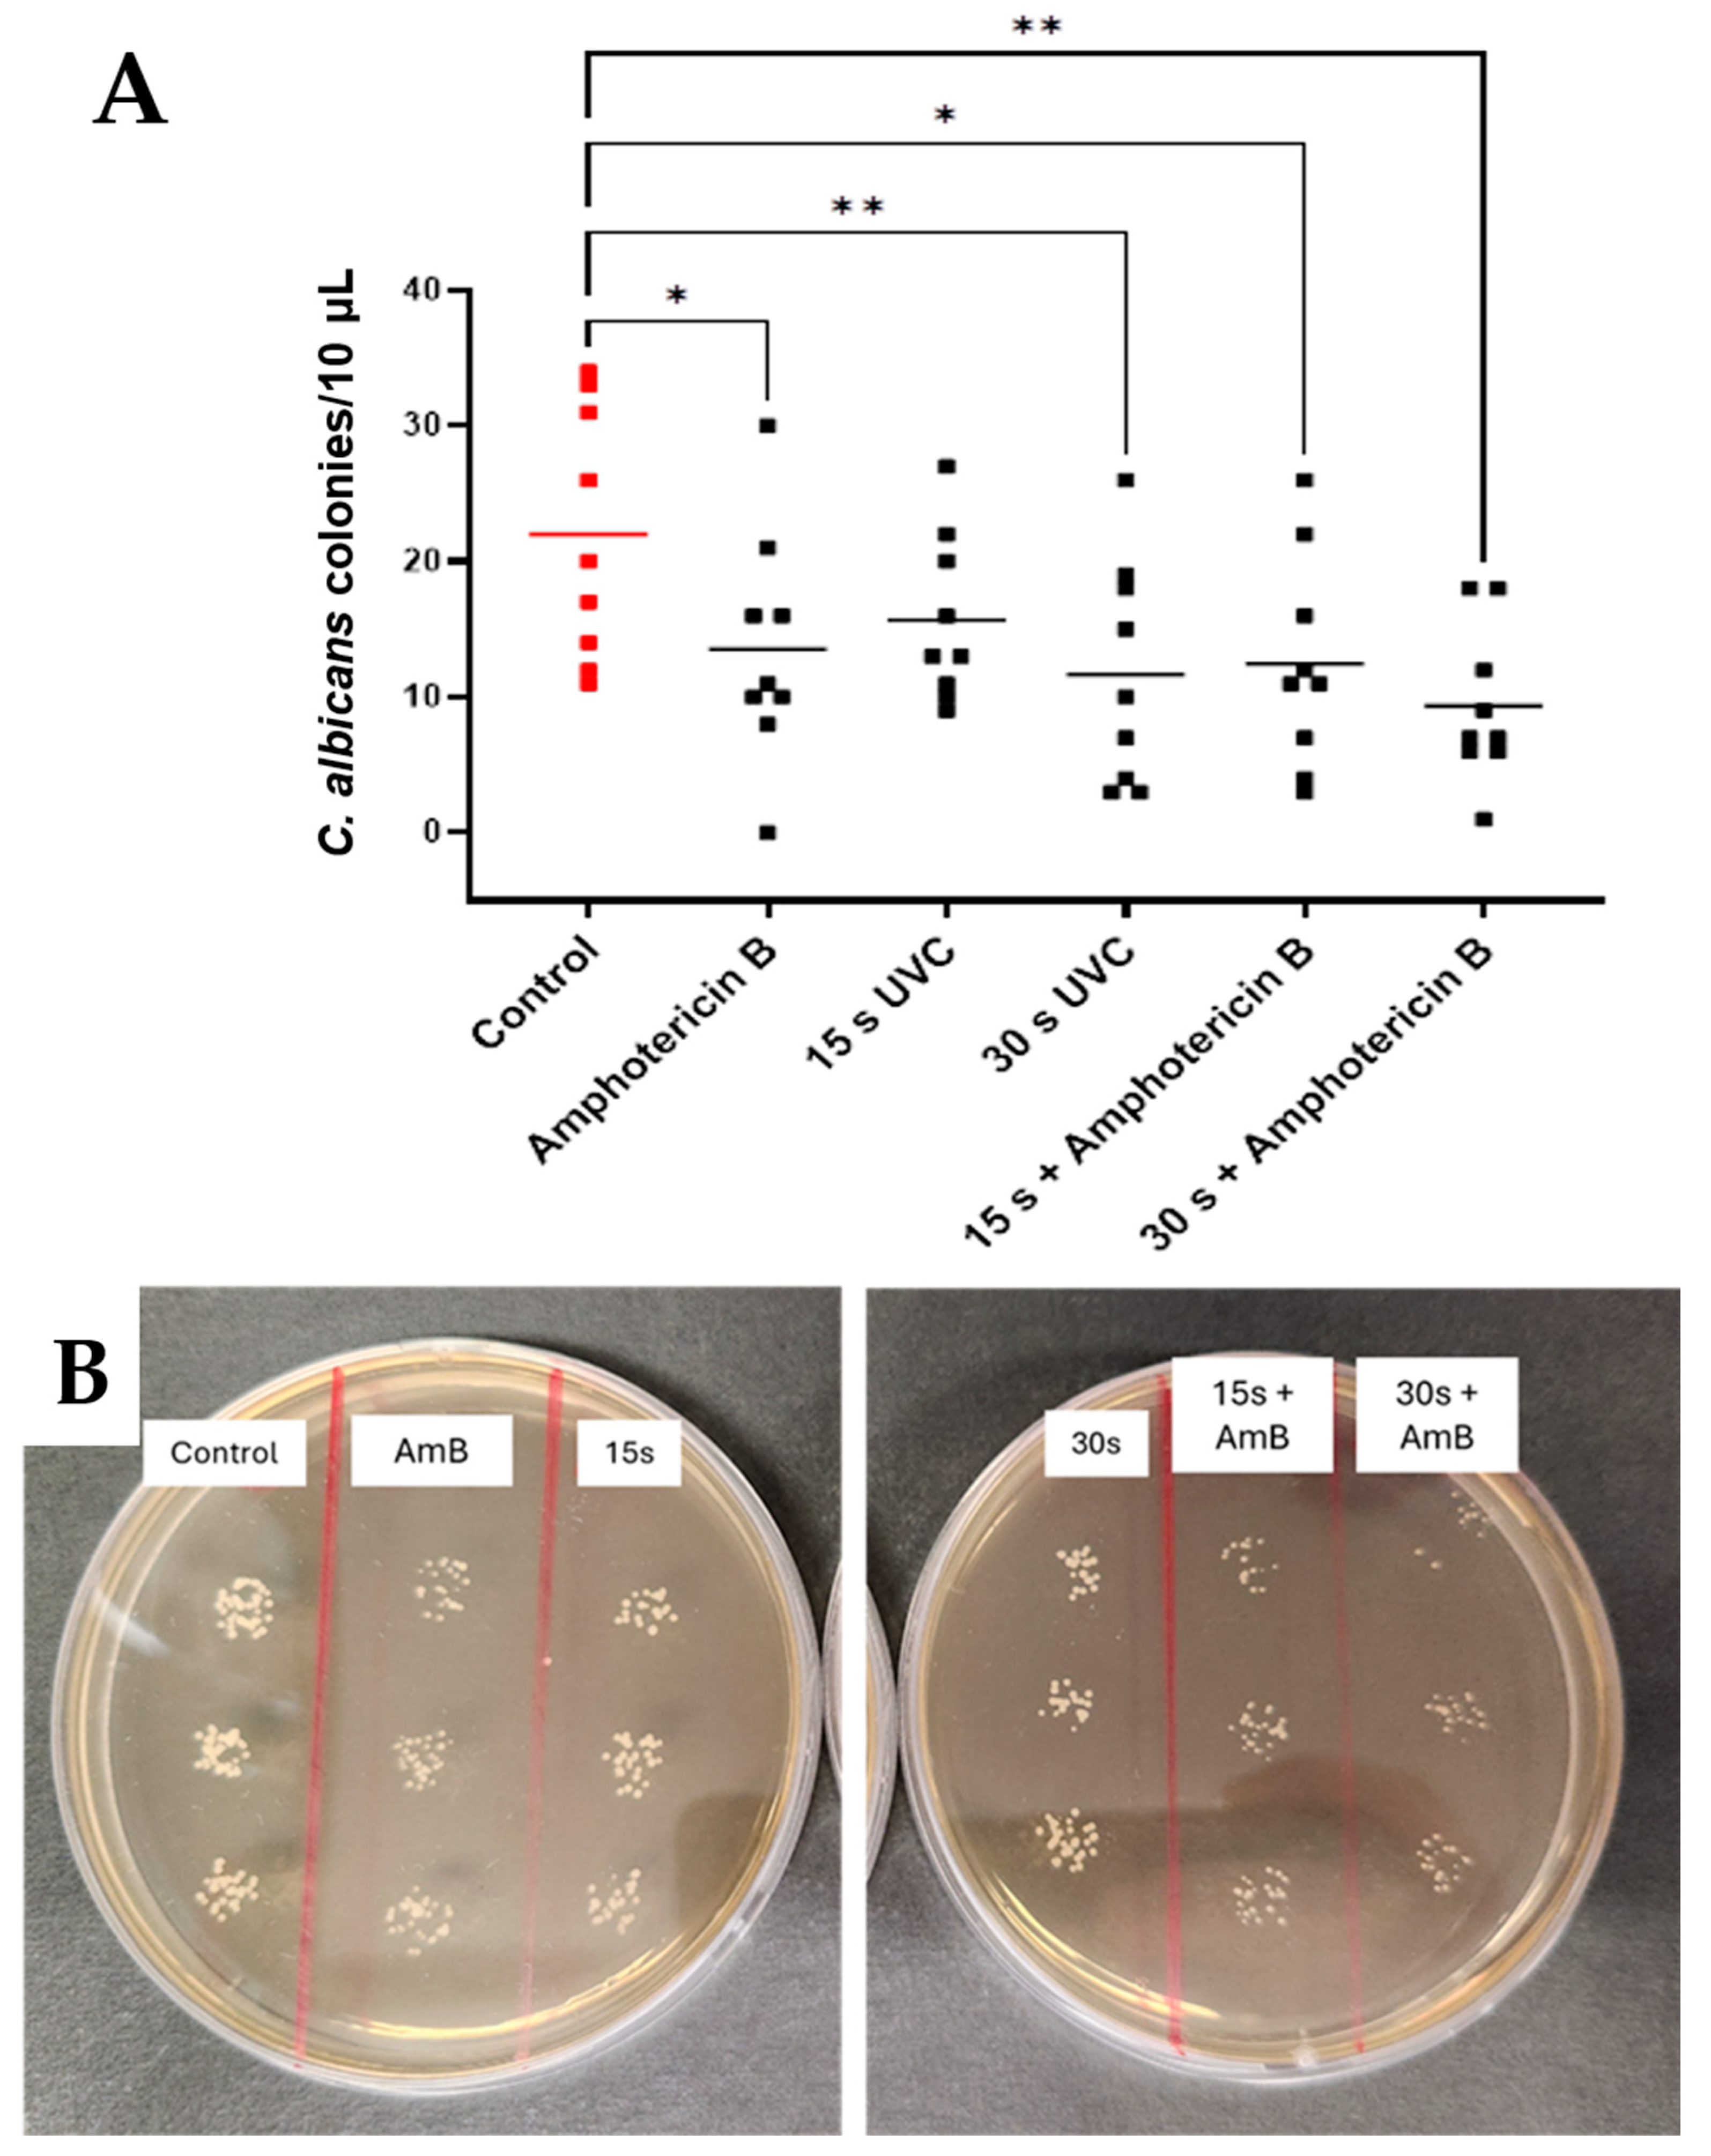
Antibiotics 14 00361 g005

1. Introduction
Microbial keratitis (MK) is a major, preventable cause of blindness and vision impairment worldwide [
1]. Rapid, intensive treatment is required to manage the condition and prevent permanent vision loss [
2]. Treatment of MK primarily involves the use of antifungal drugs [
3], and, in many countries, patients are often left with long-lasting visual impairment due to the inaccessibility of expensive treatment routes [
4]. The development of antifungal resistance by MK pathogens adds further difficulties [
5,
6,
7]. For these reasons, it is increasingly attractive to establish therapeutic pathways that effectively treat a wide range of infections and are less prone to microbial resistance. Ultraviolet (UV) light has been used safely and effectively in the treatment of a wide range of corneal conditions and ectatic diseases such as keratoconus [
8]. In the latter case, UV light (370 nm) is used to excite riboflavin, a chemical substrate, to induce a photodynamic reaction, in the procedure known as corneal collagen cross-linking [
9,
10]. This method not only treats corneal ectatic diseases but also microbial keratitis through the production of free oxygen radicals [
11]. Previous work by our group has demonstrated the efficacy of treatments that use short wavelength (265 nm) UV light alone, classed as UVC, for treating bacterial infections in vitro and in vivo [
12]. UVC’s antimicrobial action is attributed to its ready absorbance by microbial DNA, causing cross-linking of adjacent base pairs by photochemical reaction, ultimately resulting in cell death [
13,
14]. Therefore, no additional chemical substrate is required to inhibit microbial growth using this wavelength of light.
While the efficacy of UVC to treat bacterial corneal infections has been previously established in preclinical studies, many cases of MK are due to infections caused by fungal agents such as
Candida and
Aspergillus species [
15,
16,
17]. Since differentiating the causative infective organism on clinical presentation is challenging and time-consuming, and the confirmatory laboratory diagnostic testing can result in delayed treatment, it would be valuable to establish whether UVC has broad-spectrum capabilities to be used as an empiric treatment.
Pathological fungi typically present as yeasts or molds and often require more intensive treatment than bacteria due to their ability to form hyphae and grow in deeper tissues [
18]. To simulate a subsurface infection where fungi grow both on and beneath a surface, we created an in vitro model in which fungi were mixed with molten, nutrient-rich agar. As the mixture cooled to room temperature, it formed a semi-solid droplet, effectively representing a fungal corneal infection model with nutrient-rich medium. The treatment efficacy was tested in this model. Given UVC’s limited depth penetration through a medium [
19], the efficacy of UVC in inhibiting fungal growth is currently unknown. Therefore, the study aimed to evaluate the antifungal efficacy of UVC against
Candida albicans and
Aspergillus brasiliensis, fungi associated with MK [
15]. Additionally, the study investigates the potential synergistic effects of combining UVC with antifungal agents, natamycin, or amphotericin B.
2. Materials and Methods
2.1. Microbe Preparation
Suspensions of C. albicans were prepared by inoculating 10 mL of Difco yeast peptone dextrose broth (YPD, Fort Richard, Auckland, New Zealand) with 2–3 colonies of C. albicans ATCC 10231, acquired from the American Type Culture Collection (Manassas, VA, USA), and incubating overnight at 37 °C with shaking (200 rotations per minute, rpm). After 18–20 h, the suspension reached 108 colony-forming units (CFU)/mL. The following day, the suspension was centrifuged at 2500 rpm for 10 min, the broth was replaced with sterile saline, and the process was repeated to resuspend C. albicans in fresh saline.
A. brasiliensis ATCC 16404, also acquired from the American Type Culture Collection, was cultured on Difco yeast peptone dextrose agar (Fort Richard, Auckland, New Zealand) for 2–3 weeks at 26 °C. Spores were collected by gently scraping them from the agar surface but without filtering into 10 mL sterile saline with an L-shaped spreader rod. The resulting suspension was pipetted into a 50 mL V-bottom tube and thoroughly vortexed, which obtained the saturation point of 107 spores/mL when counted by a haemocytometer.
2.2. UVC Light Source
The light-emitting diode (LED) has a fixed intensity of 1.93 mW/cm
2, projecting a 4.5 mm diameter spot at 8 mm distance [
12]. The LED (SETI UVTOP265) emits at 264.5 nm with a 12.3 nm halfwidth (Hopoocolor OHSP-350UV, Hangzhou, China). At 8 mm distance, the beam has a homogeneous flat-top profile, verified by fluorescence photography and beam profiling in ImageJ (version 1.54), showing consistent exposure across the 4.5 mm diameter with rapid intensity fall-off at the edges. Exposure durations were controlled by an electric timer (dose = intensity × duration).
2.3. Preparation of In Vitro Fungal Keratitis Model
An in vitro infection model simulating subsurface corneal infections was adapted from previous work using
Pseudomonas aeruginosa [
12]. In brief, 100 µL of either
C. albicans (10
7 cells) or
A. brasiliensis (10
6 spores) was mixed with 1 mL of warm molten YPD top agar (0.75%
w/v agar in YPD) and aliquoted into a 96-well flat-bottom microplate. Three 5 µL (containing 10
5 cells of
C. albicans or 10
4 spores of
A. brasiliensis) were added to the center of each well. Once solidified, the droplets formed a circular subsurface fungal corneal infection model, which was used to assess the therapeutic potential of UVC, both alone and combined with conventional antifungal drugs, in three independent experiments. The experimental protocol has been represented graphically in
Figure 1.
2.4. Therapeutic Efficacy of UVC Alone
Agar droplets were exposed to UVC for 0 s (control), 5 s, 10 s, 15 s, 30 s, 60 s, or 120 s. After exposure, droplets were dissolved in 300 µL saline by crushing and vigorous pipetting, then transferred to 700 µL sterile saline for a final volume of 1 mL. For C. albicans, the mixture was diluted 1:10, and 10 µL was plated on YPD agar and incubated at 37 °C for 24 h for colony counting. For A. brasiliensis, the mixture was diluted 1:2, and 50 µL was plated on YPD agar and incubated at 26 °C. After 40–42 h of incubation, spores were counted individually based on their fringe or star-shaped appearance.
2.5. Therapeutic Efficacy of UVC Plus Antifungal Drugs
To assess the potential synergistic effect between UVC and traditional antifungal agents, an objective drug dosage standard was established at a sub-inhibitory concentration. The minimum inhibitory concentrations (MIC) [
20] of amphotericin B and natamycin were determined as both are commonly used in treating fungal keratitis worldwide [
17,
21]. The MIC determined in YPD broth conditions (liquid medium) was used to establish the objective drug dosage for the combination therapy in the semi-solid in vitro infection model described above.
2.5.1. MIC Assays of Antifungal Drugs
To determine MICs, both natamycin and amphotericin B were dissolved in DMSO. Natamycin was prepared at a stock concentration of 1 mg/mL and amphotericin B at 5 mg/mL in DMSO. These stock solutions were stored and subsequently diluted to working concentrations using serial dilution as needed. Three columns of a sterile 96-well plate were designated as technical repeats. The lower 7 rows of each column were filled with 50 µL of YPD broth. Then, 100 µL of either natamycin or amphotericin B was added to the top row. Serial dilutions were performed by transferring 50 µL from the top row to the row below, diluting the concentration at each step. The final row had a 50 µL volume after discarding the excess solution. A 50 µL sample of C. albicans or A. brasiliensis at 106 CFU/mL was added to each well and incubated overnight in a sealed, humidified container. C. albicans was incubated at 37 °C at 200 rpm, while A. brasiliensis was incubated at 26 °C with shaking. After 24 h, optical density was measured at 600 nm using a VICTOR Nivo Multimode Plate Reader (PerkinElmer, Waltham, MA, USA) to determine the MIC, defined as the lowest dose that inhibited growth. Here, we took a reduction in turbidity of at least 90% (i.e., MIC90) to indicate growth inhibition.
2.5.2. Antifungal Efficacy of Combined Treatment
The MICs of the drugs were determined to be as follows: 0.1875 µg/mL for amphotericin B against C. albicans, 6.25 µg/mL against A. brasiliensis, and 0.78125 µg/mL for Natamycin against C. albicans, 7.8125 µg/mL against A. brasiliensis. Once MIC doses of both drugs were established in liquid broth, the agar droplet technique was used to study the combined effects of antifungal drugs and UVC. Droplets were exposed to antifungal drugs only, 15 s or 30 s UVC, 15 s or 30 s UVC + drug, or no treatment (control). Natamycin (10 µL) and amphotericin B (100 µL) were applied at their MICs, with UVC delivered first for combined treatments. After one hour, droplets were homogenized in saline, serially diluted, and plated for microbial enumeration. In preliminary tests evaluating the antifungal efficacy of natamycin and amphotericin B at their respective MICs using the in vitro semi-solid infection model, 10 µL of each drug was applied to assess treatment effectiveness compared to an untreated control. The results indicated that while 10 µL of natamycin demonstrated the desired partial efficacy in inhibiting fungal growth at its MIC, a higher volume of amphotericin B was required to achieve similar effects. Consequently, the antifungal volumes were adjusted accordingly for each drug.
2.6. Assessment of UVC Effectiveness Against C. albicans Ex Vivo
As a step toward future testing for potential clinical translation in an in vivo model with active immunity, the goal of the current experiments was to explore the in vitro findings using an ex vivo porcine keratitis model. Corneal integrity was assessed visually to confirm that the epithelium was intact, and any eyes with epithelial damage were excluded. Intact corneas were dissected from tissue blocks, leaving a small radius (~2 mm) of limbal tissue, then stored in sterile phosphate-buffered saline (PBS). After washing with warm water for one minute, they were dipped in 5% povidone iodine, followed by three PBS washes, and stored in sterile PBS at 4 °C for up to one week. Then, the ex vivo porcine corneas were inoculated with C. albicans to evaluate UVC treatment efficacy in postmortem tissue sourced from a local slaughterhouse.
Processed corneas were placed on a petri dish with the epithelium facing up and debrided using an Alger Brush (The Alger Company Inc., Lago Vista, TX, USA) to create a 2 mm circular wound. A 10 µL saline solution containing 106 CFU of C. albicans was applied to the wound, and the corneas were incubated at 37° C for 2 h. After three washes with sterile PBS, the corneas were exposed to one of the following treatments: 0 s (control), 15 s, or 30 s UVC. The treated region was excised using a 2.5 mm diameter biopsy punch, homogenized in 2 mL sterile saline using a Multi-Gen 7XL homogenizing package (Thomas Scientific, Swedesboro, NJ, USA), and 50 µL plated on YPD agar. After 24 h at 37 °C, CFU were counted. The experiments were performed in triplicate over three days.
2.7. Statistical Analyses
Data were confirmed for normality using the Shapiro–Wilk test in GraphPad Prism Version 9.3.1, and a one-way ANOVA with multiple comparisons was applied to compare treatment efficacy across the treatment groups. A threshold of p < 0.05 was considered statistically significant.
4. Discussion
Candida and
Aspergillus species are among the predominant species implicated in MK, a corneal infection, [
22,
23] and represent a strong starting point for understanding the efficacy of this therapy in the realm of fungal keratitis management.
C. albicans and
A. brasiliensis were tested as model pathogens in the present study. The data presented here strongly indicate an inhibitory effect of UVC exposure on both fungal species tested in an in vitro fungal corneal infection model. Efficacy was dependent on UVC exposure duration, with
A. brasiliensis responding to exposures as low as 10 s and both species responsive to exposures of 15 s and longer. For both species, there was also no significant difference seen in outcomes in exposures beyond 30 s, indicating that any compounding effects of further treatment may not be sufficient to warrant risks imposed by excessive UVC exposure. In clinical practice, use of an empiric dosing strategy that demonstrates broad effectiveness against a wide range of pathogens is preferable to avoid reliance on awaiting test results to identify specific species, which may delay treatment onset. Thus, it would be valuable to compare 15 s UVC, which has been previously established preclinically to treat bacterial keratitis [
12], with 30 s UVC in further in vivo studies to establish the optimal dose that offers a “broad spectrum” antimicrobial treatment.
These findings support and expand upon prior studies that have demonstrated a therapeutic effect of direct UVC exposure to a range of pathogens in numerous experimental settings [
12,
24,
25,
26]; however, this is the first study to examine the effect of UVC in a subsurface infection-like in vitro model. Previous testing with this model demonstrated an optimum dose at 15 s for bacteria, so it may be necessary to expand the dosing strategy when fungal infections are suspected or if seeking a “one-size-fits-all” treatment strategy. To this end, further safety testing may also be beneficial. In previous studies, safety assessments were performed based on 15 s treatment according to bacterial susceptibility, which suggested that in a single application or in a cumulative dose of 45 s over three days, such UVC exposure was safe in terms of DNA defects in the mouse model tested. These data highlight the likely safety of 30 s UVC but determining the upper safe limit of therapeutic UVC in managing corneal infections would be valuable if repeated exposures are required [
19].
Pharmacological treatment remains the gold standard for MK pathology, and UVC treatment shows potential as an appealing adjunct therapy in clinical practice. Dual-therapy treatments can serve to limit the dose of individual components required for equal or superior combined efficacy, enhancing the safety profile of the overall treatment [
27]. Thus, to this end, we aimed to study the effect of UVC in concert with drug treatment.
The MICs of each drug were established as a relevant baseline from which to study the efficacy of UVC in an in vitro environment, such that clinical doses of the drug did not eliminate the colonies of exposed microbes outright. Exposure to combined therapy methods in both fungal species showed significant effectiveness at both 15 s and 30 s, relative to control, for A. brasiliensis exposed to natamycin and for C. albicans exposed to amphotericin B. At a minimum, the study confirms that the method is effective in reducing fungal growth and does not adversely affect drug efficacy.
Furthermore, a significant reduction in spore formation was seen in the 30 s combined-treatment group with A. brasiliensis and natamycin, indicating that combined treatment was more effective than drug treatment alone in this species. While the same was not seen in the Candida-Amphotericin B group, it was observed that, where Candida samples were not responsive to 15 s of UVC alone, they became responsive to this exposure duration when also exposed to drugs in the combined-treatment study. This may indicate that, while combined therapy does not necessarily enhance the efficacy of the treatment outcome with this drug and microbe combination, it may allow for efficacy at a lower dose of UVC, which may reduce the risk associated with longer exposure periods, improving the overall safety profile, and allowing benefits from shorter exposures. The latter is particularly beneficial because shorter treatment is more practical in a clinical setting and is, therefore, more appealing to both clinicians and patients. Overall, these data suggest the value of further study involving combined treatments, especially using amphotericin B for the treatment of C. albicans infection and natamycin for A. brasiliensis infections.
The effect of UVC on tissue that had been inoculated ex vivo was studied to understand how outcomes might translate to a more clinically relevant setting than can be achieved in vitro. The availability of quality tissue and the methodological difficulties that followed presented challenges and limitations for applying the method broadly, and this meant that an equivalent protocol for A. brasiliensis could not be established in these experiments. However, with C. albicans, some evidence emerged to indicate the therapeutic effect of UVC in the ex vivo infection model. An overall trend toward reduced expression is seen in the data, with significance met at the 90% level (p = 0.0577). This is most likely due to the high degree of variability seen in the distribution of data points. Variability is not unusual with microbial samples due to the nature of living organisms, but the limitations imposed by processing ex vivo tissue may need to be countered by highly powered studies or refinements in the methodological techniques.
Managing yeast and fungal infections can be challenging due to the presence of slowly growing hyphae [
28]. Consequently, the in vitro and ex vivo infection models used in these experiments may not fully represent the slowly progressing fungal infections that take time to show clinical signs. UVC light’s limited penetration through the cornea [
19] highlights the benefit of combining it with antifungal medications, as supported by the current study’s data. These results suggest that UVC could be a promising empirical treatment for microbial keratitis, applied directly at the infection site after tissue debridement and sample collection for laboratory cultures [
29]. Given that fungal corneal infections are typically not confirmed until later in their progression, early UVC application as soon as an infiltrate appears may improve treatment outcomes as an empirical approach, inhibiting microbial growth regardless of the infection’s origin. UVC’s limited corneal penetration also reduces off-target damage [
30], and its efficacy against fungal pathogens can be enhanced through debridement and combination with antifungal drugs. Additionally, when compared to other phototherapeutic techniques, UVC acts without other agents, whereas other photodynamic procedures, e.g., corneal collagen cross-linking, require UVA and riboflavin for their antimicrobial effects [
9,
10].
In our previous research, we tested a broad range of microorganisms using agar plates as surface lawns without considering depth factors, except when evaluating Pseudomonas aeruginosa. In the current experiments, we specifically examined the depth factor by utilizing an in vitro infection model and an ex vivo model to study infection in subcellular contexts for fungal keratitis. These new data build upon our previous in vitro studies and lay the groundwork for transitioning to in vivo research.
The potential for UVC to induce sub-inhibitory dose-induced fungal tolerance is worthy of future research. While ecological evidence shows that some microorganisms can develop tolerance to UV light and other stressors over extended periods, a recent review found limited evidence for tolerance to sub-lethal doses of light-based anti-infective treatments [
31]. However, considering ecological examples, it remains a possibility worth exploring, particularly in regard to how fungal species might respond to prolonged or repeated sub-lethal therapeutic UVC doses.